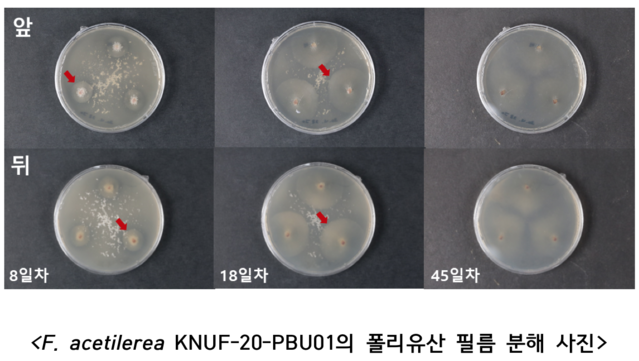
▲ ⓒ환경부

PCL·PLA 등 균주별 7~45일 이내 완전 분해 효과 확인국립생물자원관 "오염정화에 활용되도록 다양한 미생물 찾아낼 것"
-
- ▲ ⓒ환경부
폐기물 분해 기반 연구에서 바이오 플라스틱 분해를 촉진하는 곰팡이 균주가 발견돼 친환경 생태계 마련에 탄력이 붙고 있다.환경부 소속 국립생물자원관은 정희영 경북대 교수진과 공동연구로 의료용 등에 쓰이는 바이오플라스틱의 분해를 더욱 촉진하는 곰팡이 균주를 발견했다고 6일 밝혔다.이번 연구는 국내 토양에 자생하는 곰팡이를 활용하여 바이오플라스틱 폐기물을 분해하는 기반을 마련했다는 데 의미가 있다.바이오플라스틱은 자연계에서 분해되지 않는 일반 플라스틱과 달리 토양 중 미생물에 의해 생분해되지만, 일부 플라스틱은 자연계에서 완전분해가 어려워 수년 이상이 걸리기도 한다.이번 연구에 사용한 분해되기 힘든 바이오플라스틱은 ‘폴리카프로락톤 디올(PCL)’과 ‘폴리유산(PLA)’이다.연구진은 토양에 서식하는 곰팡이가 가진 물질의 분해 능력에 주목하고 국내 10여 곳의 토양에서 분리한 200여 개 곰팡이 균주를 대상으로 바이오플라스틱의 분해 능력을 확인했다.그 결과 곰팡이 ‘푸시콜라 아세틸레리아’가 PCL과 PLA를 모두 분해했고 ‘탈라로마이세스 피노필루스’는 PLA를, 효모인 ‘아피오트리쿰 포로섬’은 PCL을 분해했다.PCL 분해는 균주에 따라 7~14일 정도 걸리고 PLA의 완전분해에는 45일이 걸리는 것으로 나타났다.국립생물자원관은 분해효소 유전자 파악 등 분해 원리 연구를 추진하고 바이오플라스틱 생분해 공정에 활용하기 위해 이 균주들에 대한 특허를 최근 출원했다.배연재 국립생물자원관장은 “미생물은 분해자로 생태계 물질 순환의 큰 축을 담당하고 있다”며 “미생물이 가진 분해능력을 오염정화에 활용할 수 있도록 다양한 미생물을 찾아낼 계획”이라고 말했다.







